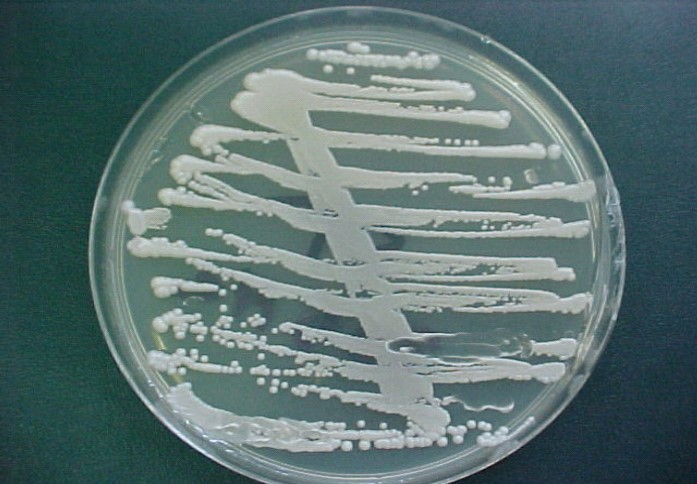

Saccharomyces Kluyveri Fungemia in a Patient with Human Immunodeficiency Virus Infection
Abstract
We report a case of a young woman with acquired immune deficiency syndrome admitted with fever and abdominal pain. Saccharomyces kluyveri was isolated in blood culture. She was successfully treated with fluconazole. This case demonstrates the pathogenicity of Saccharomyces Kluyveri in immunocompromised host.
Author Contributions
Academic Editor: Samantha Chandranath Karunarathna, Kunming Institute of Botany, Chinese Academy of Sciences, Kunming, China
Checked for plagiarism: Yes
Review by: Single-blind
Copyright © 2018 E. Elleuch, et al.
This is an open-access article distributed under the terms of the Creative Commons Attribution License, which permits unrestricted use, distribution, and reproduction in any medium, provided the original author and source are credited.
Competing interests
The authors have declared that no competing interests exist.
Citation:
Introduction
Systemic fungal infections are one of the major causes of morbidity and mortality in immunocompromised patients. Although Candida and Aspergillus species are the common fungal pathogen responsible of infection in these patients, Saccharomyces was reported as an emergent pathogen 1. It is frequently referred as brewers or baker’s yeast. Invasive Saccharomyces infections are relatively rare. It mainly presents as septicemia that resist in broad-spectrum antibiotics. Despite appropriate antifungal therapy, the disease has been associated with unfavorable outcome and a high mortality rate. We report a case of Saccharomyces (S) Kluyveri fungemia in patient with human immunodeficiency virus syndrome.
Case Report
A 32-year-old woman with acquired immune deficiency syndrome presented with a one week history of fever and abdominal pain. His medical history was significant for hepatitis C cirrhosis and Kaposi sarcoma. She presented Salmonella enteritidis septicemia one month prior to admission treated with cefotaxime during 15 days.
Seven days before admission, she presented with severe abdominal pain, asthenia and fever.
Physical examination revealed a high temperature as 39°C, pulse rate 94/min; blood pressure was 80/40 mm Hg and diffuses abdominal tenderness. Pertinent laboratory findings included pancytopenia, CD4 count as 14 cells/mm3 and HIV viral load 3, 87.105copy/ml.
Abdominal ultrasonography demonstrated hepatosplenomegaly. Trans thoracic echocardiography and chest X ray were normal.
Parasitological examination of stools and coproculture were negative.
Blood and urine specimens were collected for bacterial culture and subsequently found to be negative. Fungal Sabouraud culture of blood was positive for S. kluyveri. Figure 1, Figure 2 and Figure 3 show the macroscopic and microscopic aspects of Saccharomyces kluyveri. The strain was susceptible to all antifungal treatment. Aspergillus and leishmaniasis serology were both negative. The patient was treated with fluconazole (400 mg/day). Ten days later, she became afebrile. She received 1 month of antifungal treatment. She developed on day 17 an abdominal pain and fever. Sabouraud blood cultures performed were sterile. Bacterial blood cultures were positive to Salmonella enteritidis. A CT scan confirmed appendiularperitinotis. She underwent a surgical treatment. After her operation, the general condition of the patient worsened progressively and she persisted febrile for 12 days. She developed a respiratory distress and she died.
Figure 1.Macroscopic aspect of Saccharomyces kluyveri isolated from blood culture.
Figure 2.Macroscopic aspect of Saccharomyces kluyveri isolated from blood culture.
Figure 3.Macroscopic aspect of Saccharomyces kluyveri isolated from blood culture.
Discussion
Saccharomyces kluyveri, also named Lachanceakluyveri, is budding yeast related to Saccharomyces cerevisiae2. It is widespread in the environment and can be found on drosophila species, fruit, plants and in soil 1. It is a common colonizer of human respiratory, gastrointestinal and urinary tracts and considered as a benign organism 1. Thus, infection must be considered and patient should be treated for an invasive fungal infection when the organism is isolated from a normally sterile body site 2. Saccharomyces cerevisiae, S. carlsbergensisand S. boulardii have been associated with serious human infection. The role of S. kluyverii as human pathogen is unknown 3. To our knowledge, this is the second reported case of S. kluyverifungemia in the literature. The first case was reported in 1998. A-47-year-old man infected with human immune deficiency virus was hospitalized for fever, asthenia, defective memory and shortness of breath. He was diagnosed with disseminated S. kluyveri infection. The yeast was isolated from blood cultures and CSF. The autopsy revealed the presence of the microorganism in different organs: liver, spleen, pancreas, lungs, kidneys and brain 3.
Systemic infections in immunocompromised patients are uncommon as compared to invasive aspergillosis and candidiasis. The incidence of Saccharomyces fungemia is unknown; it varied from 0.1% to 3.6% of all episodes of fungemia 2, 4. Hospital-acquired transmission has been demonstrated 2, 4, 5, 6.
Risk factors are nearly the same of systemic candidiasis. They mainly include deep and prolonged neutropenia, immune cell deficiency, broad- spectrum antibiotics, cytotoxic chemotherapy, parenteral nutrition, hemodialysis and catherization 1, 2, 5. The use of probiotic is an important risk factor for fungemia which may be especially dangerous in patients at high risk for infection 1, 4, 6. It was responsible for 40.2% of invasive Saccharomyces infections reported in the literature 1. In our case, the acquired immune cell deficiency (HIV) was noted associated with the use of broad- spectrum antibiotics. She did not receive any dietary supplementation or probiotic preparations. The portal of entry is mainly supposed to be digestive 1. In our patient, no clear portal of entry has been defined.
The main clinical presentation is similar to other invasive fungal infections as a fever unresponsive to antibiotics.Non specific symptoms are usually noted and can roam the diagnosis and delay support. Saccharomyces spp. can cause a wide variety of clinical syndrome, such as genitor-urinary tract infection, gastro-intestinal infection (peritonitis, eosophagitis and liver abscess), respiratory infection, endocarditis and septic shock 4, 7, 8.
The diagnosis is based on positive blood cultures and also the mycological and pathological examinations of organ biopsies guided by clinical symptoms.
The identification of the fungus in cultures is simple and is based on its unique morphology, growth and biochemical aspects. 7
ESCMID and ECMM suggested treatment guidelines for S. yeast based on his sensitivity profile studied in vitro and in reference to the data of the few cases reported in the literature. 10
Saccharomyces sensitivity profile is similar to C. glabrata. It has a high MICs to fluconazole and low MICs to Amphoterecin B and Flucytosine. S. is claimed susceptible to Amphoterecin B and Flucytosine and has a reduced susceptibility to fluconazole. Echinocandins are active on Saccharomyces. Despite the fact that data are scarce, both posaconazole and voriconazole have been reported to have good activity in vitro against this fungus 4.
Amphoterecin B is the antifungal of choice in the treatment of these infections. 4, 9, 10, 11
Besides, no therapeutic failure has been clearly attributable to resistance, even in strains with reduced susceptibility to fluconazole, it has been proposed as an alternative to Amphoterecin B.4, 9
In our case, our patient was successively treated with fluconazole during one month.
Despite this spectrum of susceptibility, a favorable outcome was observed in 63% of cases, which is a slightly higher percentage than that reported for cases of invasive candidiasis 4.
In conclusion, Saccharomyces organisms are increasingly reported as agents of invasive infection, especially in immunocompromised or critically ill patients.
References
- 1.Enache-Angoulvant A, Hennequin C.Invasive Saccharomyces Infection: A Comprehensive Review ; Clinical Infectious Diseases ;. 41(11), 1559-1568.
- 2.Pillai U, Devasahayam J, Kurup A N, Lacasse A. (2014) Invasive saccharomyces cervicae infection :a friend turning foe ?; Saoudi journal of kidney disease and transplantation. 24(6), 1266-1269.
- 3.Pynka M, Wnuk A, Bander D, Syczewska M, Boroń A et al.Disseminated infection with Saccharomyces kluyveriin a patient with AIDS. , Infection.1998May-Jun 26(3), 184-6.
- 4.Munoz Patricia, Bouza Emilio, Cuenca-Estrella Manuel, MarïaEiros Jose, Maria Jesus Pérez et al.Saccharomyces cerevisiae Fungemia: An Emerging Infectious Disease; Clinical Infectious Diseases.2005Nov1. 40, 1625-34.
- 5.Marisa H Miceli, Diaz J A, Samuel A Lee. (2011) Emerging opportunistic yeast infections; Lancet Infect Dis. 11, 142-51.
- 6.Shadi Hamoud MD, Zohar Keidar MD, Tony Hayek MD. (2011) Recurrent Saccharomyces Cerevisiae Fungemia in an Otherwise Healthy Patient. , IMAJ 13, 575-576.
- 7.Fernando Ribeiro Paco, Silva FH Alves da, Reis Eduardo, Amaral Vinicius. (2011) . Saccharomyces cerevisiae infection – an unusual pathogen in the ICU, Rev Bras Ter Intensiva 23(1), 108-111.
- 8.Ossama W Tawfik, Christopher J Papasian, Anita Y Dixon, Lonna M Potter.Saccharomyces cerevisiae Pneumonia in a Patient with Acquired Immune Deficiency Syndrome. , Journal Of Clinical Microbiology.July1989 1689-1691.
- 9.Aucott J N, Fayen J, Grossnicklas H, Morrissey A, Lederman M M et al.invasive infection with saccharomyces cerevisiae : report of three cases and review, rev inf dis1990may-june. 12(3), 406-11.
